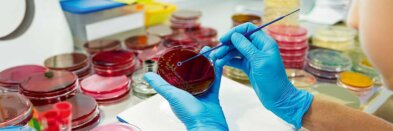
Mikrobiologe

Zellbiologie – Studium, Karriere & Gehalt
Zellbiologie ist die Wissenschaft von Aufbau, Funktion und Interaktion lebender Zellen. Sie untersucht sowohl die Struktur von Zellorganellen als auch Prozesse wie Zellteilung, Signalweiterleitung und Stoffwechsel. Dabei werden Zellen als grundlegende Einheit des Lebens betrachtet, aus denen alle Organismen bestehen. Zellbiologische Forschung nutzt moderne Methoden wie Fluoreszenzmikroskopie, Zellkultur und molekularbiologische Techniken. Ziel ist es, die zellulären Grundlagen von Gesundheit, Krankheit und Entwicklung besser zu verstehen.
Zum Artikel